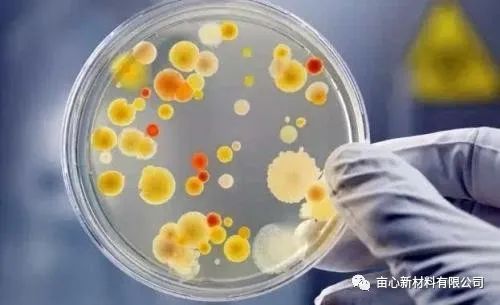
3.jpg

畝心新材料國(guó)慶鉅獻(xiàn)——抗菌添加劑
The National Day offering by Resin&Zircon New Material Ltd. ---Anti-bacterial Additive:
2022-02-25
想知道為什么都說(shuō)吃剩飯剩菜吃了會(huì)不健康嗎?想知道為什么蔬菜水果之類的放置一段時(shí)間后會(huì)長(zhǎng)白毛變得特別惡心嗎?想知道為什么酸奶會(huì)有那么獨(dú)特的口感嗎?

這就是今天的絕對(duì)主角-微生物。這是一個(gè)存活在地球三十億年的古老產(chǎn)物,它也是曾經(jīng)地球上唯一的生命形式,它們占據(jù)了陸地、天空、水體的每一個(gè)角落,推動(dòng)著化學(xué)反應(yīng),創(chuàng)造了生物圈,并為多細(xì)胞生命的演化創(chuàng)造了條件。這就是微生物的時(shí)代,過(guò)去如此,現(xiàn)在如此,將來(lái)亦如此,直至世界終結(jié)。② 微生物的分類而微生物較大多數(shù)屬于非致病性甚至有益性微生物,廣泛存在自然界、人體皮膚粘膜表面等。微生物里面其中最常見(jiàn)的就是細(xì)菌啦。細(xì)菌與人類生命息息相關(guān),它們?cè)谌梭w的每個(gè)角落,皮膚表里,所有器官中,管控著我們的味覺(jué)、情緒、情欲甚至思維,讓我們歡喜讓我們憂。各種各樣的微生物不僅在外型上有如此之大的差別,在實(shí)際生產(chǎn)、生活中的作用更是千差萬(wàn)別,如傷寒桿菌可以引起傷寒病,痢疾桿菌可引起痢疾病,霍亂弧菌可引起霍亂等等危害人與牲畜的健康。可是,不是所有的微生物都是這樣可怕,如適量的乳酸菌在人的腸道中可以有助胃腸的消化;部分放線菌可制成抗生素以抵抗病毒的浸染;微生物還可以用來(lái)釀酒、做面包、淹浸酸菜等等。大多數(shù)的細(xì)菌在我們降生時(shí)便開(kāi)始進(jìn)入我們的身體,在身體中繁衍生息,與我們和平共處,沒(méi)有它們,我們將無(wú)法生存。但細(xì)菌里面還是有壞成員-致病菌,致病微生物是指能引起動(dòng)物植物的某些疾病的微生物,占少類,比如流感病毒可以起人類、禽類的流感。另外有的一部分是條件致病菌。③ 抗菌材料發(fā)展目前,由細(xì)菌感染引起的生存環(huán)境的惡化也越來(lái)越引起廣泛的關(guān)注和重視。

因此,使用抗菌材料和抗菌劑來(lái)抑制有害細(xì)菌的繁殖和生長(zhǎng),對(duì)于減少疾病、保護(hù)人類健康具有非常重要的意義??咕鷦┦侵改軌蛟谝欢〞r(shí)間內(nèi),使某些微生物(細(xì)菌、真菌、酵母菌、藻類及病毒等)的生長(zhǎng)或繁殖保持在必要水平以下的化學(xué)物質(zhì),這種材料對(duì)人類的抗菌事業(yè)發(fā)展至關(guān)重要,從古至今人們都在尋找更好的抗菌材料。從遠(yuǎn)古時(shí)代人們就開(kāi)始使用抗菌材料,人們發(fā)現(xiàn)用銀和銅容器留存的水不宜變質(zhì),后來(lái)皇宮中的貴富人吃飯時(shí)又習(xí)慣使用銀筷子,民間又用銀制成飾品佩帶,我國(guó)民間很早就開(kāi)始認(rèn)識(shí)到銀有抗菌作用。根據(jù)抗菌劑化學(xué)組成的不同,抗菌劑主要可以分為無(wú)機(jī)抗菌劑、有機(jī)抗菌劑和天然抗菌劑三大類,這些抗菌劑在抑制細(xì)菌繁殖和生長(zhǎng)方面能力不同,有著各自的優(yōu)缺點(diǎn)。但是,傳統(tǒng)的抗菌劑在長(zhǎng)期使用的過(guò)程中出現(xiàn)了各種各樣的問(wèn)題,比如:溶出快、抗菌有效期較短、耐候性較差、易變色、易團(tuán)聚,且部分抗菌劑對(duì)皮膚刺激性較大、抗菌譜較窄,長(zhǎng)期使用還可能導(dǎo)致耐藥菌株的出現(xiàn)。
畝心新材料國(guó)慶鉅獻(xiàn),推出復(fù)合材料抗菌添加劑,可實(shí)現(xiàn)持續(xù)抗菌。該抗菌劑離子交換能力和離子親和性、耐酸堿腐蝕以及耐高溫性、并且層板間可以根據(jù)需要進(jìn)行功能化處理,達(dá)到較好的抗菌效果并且克服了單一抗菌劑的缺點(diǎn),能很好地滿足抗菌性能、耐熱性、耐久性和安全性的要求,非常適用于高鍛燒結(jié)的抗菌制品。

其抗菌過(guò)程可以分為4個(gè)階段:同微生物接觸;同細(xì)胞膜相互作用并引起膜的透化;胞內(nèi)殺死階段;微生物死亡。
畝心新材料復(fù)合抗菌劑可以添加在塑料,橡膠,纖維,涂料,紙張,膠粘劑,陶瓷和玻璃中制備抗菌功能材料,可制成銀鋅無(wú)機(jī)抗菌劑,稀土復(fù)合無(wú)機(jī)抗菌劑,抗菌纖維母粒,織物抗菌整理劑,羽絨抗菌除臭整理劑。